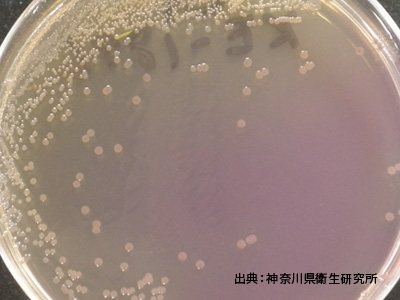
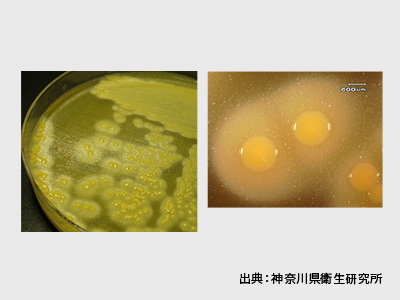
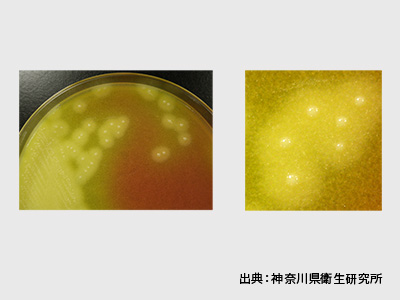

食中毒に気をつけよう!
食中毒ってなあに?
ばい菌がついた食べ物や毒がある食べ物を食べると、お腹が痛くなったり、熱が出たり、吐くなど体の調子が悪くなることがあるよ。これを食中毒というよ。

どうして食中毒になるの?
食中毒の原因となるものは細菌、ウイルス、寄生虫、毒などいろいろあるよ。
特に細菌による食中毒が多いけど、細菌は目に見えないくらい小さく、温度など条件がそろうと食べ物の中で増えていき、その食べ物を食べると食中毒になることがあるよ。

食中毒かもとおもったら
早めに病院に行って、お医者さんにみてもらいましょう。
かぜや他の病気と間違えてしまうこともあるから注意してね。
クイズに挑戦!
これでみんなも食中毒ハカセ!
外から帰ってきて、テーブルにおいしそうなごはんがあったよ。最初にやることは?

A
いただきまーす
B
まずは手を洗う
お肉を食べる時にきをつけることは?

A
生焼けのまま食べる
B
中までしっかり焼く
食中毒予防の3つのお約束は「つけない」「増やさない」あとひとつは?

A
やっつける
B
気を付ける
焼肉をするときは、焼いていない肉と焼いた肉を一緒のおはしを使っても問題ない?

A
OK
B
別のおはしを使う
もっと学びたいそこのキミ!
食品表示について学ぼう!
食品表示ってなあに?
みんなが食べているお菓子は、たくさんの材料を使って作られているよ。そのお菓子には、どんな材料が入ってるか、いつまでに食べればいいのかなどが書いてあるところがあるんだ。それが食品表示だよ!

クイズに挑戦!
これでみんなも食品表示ハカセ!
賞味期限とは、何の期限のこと?
A
その食品を安全に食べられる期限
B
その食品をおいしく食べることができる期限
原材料名は、どんな順番で書かれている?
A
その食品の中に入っている重量が多いものの順番
B
アイウエオの順番
もっと学びたいそこのキミ!
みんなの質問コーナー
添加物ってなあに?
食品を長持ちさせたり、形を保ったり、味や色や香りをつけるために使われているよ。使ってもよい添加物は、国で決められているんだ。
火を使うのはこわいから、電子レンジで加熱してもいいですか?
電子レンジは手軽に食品を温められるけど、焼いたり揚げたりするのに比べて加熱にムラができやすいよ。食品全体に熱が伝わるように、ときどき混ぜながら、何回かに分けてレンジしよう。
- TOP
- キッズページ